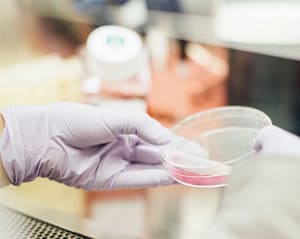
Graviola funciona com todos os tipos de tumores?

O que é a Graviola e como é usada?

Tudo o que precisas de saber sobre como a graviola previne e cura o cancro
O cancro pode ser considerado a maior epidemia do século XXI. Todos nós conhecemos algumas pessoas do nosso ambiente mais próximo que sofrem ou sofreram com esta doença; às vezes é a nossa vez…. Seja como for, podemos fazer muito para não só ajudar o nosso próprio processo de cura, mas também para prevenir a chegada de uma doença tão terrível. Os componentes que a natureza nos dá são um presente que não podemos ignorar e esta planta medicinal está a demonstrar, estudo após estudo, ser um dos suplementos naturais mais benéficos para os nossos tratamentos e para prevenir muitos tipos de cancro.

O que é a Graviola?
Este remédio natural, cujo nome científico é Annona muricata, é uma árvore encontrada nas florestas tropicais da América Central e do Sul. Dá um fruto também conhecido como catuche, gravioleira, corossol, stachelannone, sinini, guanaba ou papaia brasileira. É verde e espinhoso, a sua polpa fica do sabor do morango e abacaxi e quando aberta é semelhante à anona.
A gravioleira, assim como a casca, as raízes e as folhas são usadas desde a antiguidade como remédio natural pelos nativos americanos, do Brasil, Peru ao México. O Ocidente, tanto os Estados Unidos como a Europa, começou recentemente a perceber os seus incríveis benefícios anti-tumorais para tratar e prevenir o cancro incluídos neste artigo, bem como outras doenças, e hoje decidimos fornecer-te um resumo do que estás a perder se desistires desta fruta peculiar e vamos responder a todas as tuas perguntas. Vamos começar?

Propriedades da Graviola
A propósito, este fruto em particular e todos os elementos da árvore graviola annona muricata (fruta, folhas, casca, raízes, ervas) têm uma série de benefícios muito importantes, desde a remoção dos piolhos com uma infusão preparada com as folhas até à eliminação de diarreia, parasitas, etc. Vamos listar e dar-te informações sobre alguns dos benefícios mais importantes e essenciais destas plantas medicinais que podem ajudar-te, estás pronto?

Anticancro
Sabemos que já ouviste esta palavra inúmeras vezes, apenas para ver nas notícias, pouco depois, uma manchete referente ao esquema em torno daquele medicamento anticancerígeno que eles venderam como se fosse uma terapia milagrosa ou alternativa; ou algum estudo que não é conclusivo sobre o seu poder antitumoral ou de outro elemento natural.
Bem, este não é o caso. Existem inúmeros estudos que verificam os benefícios desta planta para prevenir e ajudar (juntamente com o tratamento prescrito pelo especialista) a curar o cancro. O que esta fruta faz é prevenir a reprodução das células cancerosas e reduzir o tamanho dos tumores, as suas acetogeninas fazem este milagre. A Annona muricata atua em diferentes tipos de cancro

Propriedades antioxidantes
As propriedades medicinais dessa planta (a guanabá, outro dos seus múltiplos nomes) não se limitam ao cancro. Também provou ser um excelente antioxidante, especialmente na Coenzima Q10. Para não te aborreceres, basta teres em mente que esta Coenzima aumenta a vitalidade e a energia e ajuda a promover a função dos músculos e do coração, tomar uma dose diária traz esta propriedade para o nosso corpo.

Propriedades anti-inflamatórias
As suas propriedades anti-inflamatórias tornam-na um excelente complemento para aliviar certos tipos de dor.

Reduz os níveis de açúcar
Com a atual revolução contra o açúcar, a proliferação de casos de diabetes tipo 2 (aquele que é adquirido) e os casos de obesidade infantil que vemos diariamente, não poderíamos ignorar este remédio.
Está a ser demonstrado que o seu consumo ajuda a baixar os níveis de açúcar no sangue, regulando os níveis de glicose e dando assim um melhor nível de vida a pessoas com problemas de açúcar.
Pressão arterial

As plantas naturais estão a provar ser um tratamento muito adequado para regular e baixar a pressão arterial, e sim, a planta de que estamos a falar é altamente recomendada para tratar a hipertensão. Por favor, considera que atualmente as mortes devido a ataques cardíacos estão a aumentar no nosso país. Não há mal nenhum em tomar estes suplementos da origem natural que te ajudarão a reduzir a pressão de sangue, especialmente se sofreres deste tipo de problemas.

Previne úlceras
Outra das epidemias hoje em dia são as úlceras. Devido à vida stressante que levamos, estão a tornar-se numa doença comum. Os benefícios da gravioleira também são usados para preveni-las, pois ajuda a proteger a mucosa do estômago.

Herpes
O fruto da Annona Muricata e as folhas da sua árvore também têm sido tradicionalmente usados para tratar muitas infeções como esta irritante (e desagradável, vamos enfrentá-lo) infecção da pele que também causa muita dor àqueles que sofrem dela.
Fibromialgia

Tomar graviola, -extrato líquido de graviola-, é muito benéfico para as pessoas que sofrem de fibromialgia. Estudos recentes publicados pela Universidade de Sevilha demonstram-no e é uma grande notícia para um grupo de doentes crónicos que sofrem em silêncio com esta terrível doença.
Como é que é tirada?

É bastante simples, mas como é que a consomes de uma forma rápida e fácil? Como já dissemos antes, quase tudo da árvore é útil. Vamos rever muito brevemente como usar os seus frutos e folhas para que possas adicioná-los à tua dieta diária:
Folhas
As folhas são geralmente tomadas numa infusão e são muito saudáveis. É tão simples como colocá-las em água e levá-las a um ponto de ebulição; depois disso, deixa repousar pelo menos durante 5 minutos. Podes tomá-las como uma bebida quente ou deixá-las esfriar e andar com ela durante todo o dia. Simples e saudável!
Fruta
Se não te apetecer comer tudo, prepara um sumo delicioso. É muito simples e podes consumir esta fruta benéfica numa base diária.
Efeitos secundários
O efeito mais incrível que encontramos ao tomar gravioleira é a sua capacidade de «comer tumores», de «comer células cancerosas». Estudos estão a provar que é um potente anticancro, é ainda mais potente do que muitos medicamentos que os oncologistas prescrevem aos seus pacientes, além de ajudar a prevenir diferentes tipos de melanoma. Também é importante notar que tomar doses regularmente ajudará a tua saúde intestinal, uma vez que previne parasitas e ajuda a curar a diarreia. Por outro lado, é uma fonte incrível de vitamina C, que ajuda a fortalecer o teu sistema imunitário e a prevenir infecções. Todos estes benefícios ajudam a manter-te em boa saúde e preparado para enfrentar o teu dia-a-dia, as contra-indicações e o principal efeito secundário? Sentires-te bem. E vais consegui-lo com plantas medicinais, com um grande produto natural, que é utilizado há centenas de anos e que está agora a ser testado em estudos que certificam os seus benefícios para a saúde.
Comprar Graviola e as suas variações
Fruta Graviola
Se amas a fruta, esta será a tua melhor opção, sendo uma fruta tropical (cultivada no Peru, Colômbia, etc), às vezes é difícil encontrá-la no mercado espanhol. Podes comê-la diretamente ou podes preparar sumos. Além disso, o seu sabor tem um curioso toque a abacaxi e morango… tens de provar!
Cápsulas, comprimidos ou pó de Graviola
Se quiseres desfrutar de todos os benefícios desta fruta, mas não queres preparar sumos, infusões e não és um louco pela fruta, tomá-la como cápsulas ou comprimidos (comprimidos) é a tua melhor opção. Deves considerar como é que as pílulas são tomadas e a dosagem
Graviola formato líquido
Também podes escolher este formato, que é fácil de beber e não requer preparação. É aconselhável tomá-la de manhã com o estômago vazio e serve como um suplemento dietético; é o mais completo e recomendado e é facilmente encontrado em Espanha.
Outra opção muito simples é comprar sumo concentrado.
A melhor coisa sobre esta opção é que podes misturar um pouco deste sumo com o que bebes todas as manhãs como de costume. Desta maneira estarás a dar ao teu corpo todos os benefícios desta planta natural sem mesmo dar por ela.
Chá Graviola
Se gostas de chás, esta é a tua versão. Quer compres as folhas e as prepares tu mesmo; ou compre o chá pronto a fazer, irás desfrutar de uma chávena de chá quente que é saudável e benéfico para o teu corpo e para o teu bem-estar e beleza diários.
Em última análise, simplesmente adicioná-lo – em qualquer um dos seus múltiplos formatos – ao nosso cesto de compras semanal será algo de barato, mas com grandes benefícios. Recomendamos tomar 40 mg de extrato seco da graviola ozonizada (Graviola Prozono), não compres da Amazon já que essa plataforma não envia esses produtos. Afinal, não vamos perder nada ao tentarmos ver como esta fruta benéfica nos ajudará a melhorar a nossa saúde. Vais tentar?
O que é Graviola ou Annona muricata?
Este remédio natural, cujo nome científico é Annona muricata, é uma árvore encontrada nas florestas tropicais da América Central e do Sul. Dá um fruto também conhecido como catuche, gravioleira, corossol, stachelannone, sinini, guanaba ou papaia brasileira. É verde e espinhoso, a sua polpa fica do sabor do morango e abacaxi e quando aberta é semelhante à anona. A gravioleira, assim como a casca, as raízes e as folhas são usadas desde a antiguidade como remédio natural pelos nativos americanos, do Brasil, Peru ao México. O Ocidente, tanto os Estados Unidos como a Europa, começou recentemente a perceber os seus incríveis benefícios anti-tumorais para tratar e prevenir o cancro incluídos neste artigo, bem como outras doenças, e hoje decidimos fornecer-te um resumo do que estás a perder se desistires desta fruta peculiar e vamos responder a todas as tuas perguntas. Vamos começar?
Propriedades antiparasitárias:
A gravioleira é usada para tratar a parasitose. As parasitoses são doenças infeciosas produzidas por seres vivos, os parasitas. Podem ser encontradas no sistema digestivo humano. São comuns em todo o mundo e, embora afetem todas as idades, as crianças têm um maior risco de as obter.
Propriedades antimicrobianas:
Combate os microrganismos e inibe o seu crescimento, como bactérias, fungos e parasitas.
Propriedades antiespasmódicas:
Neste caso, é usado como medicamento (medicamento) para ajudar a combater contraturas, cãibras e convulsões no corpo.
Propriedades anti-reumáticas:
Estes servem para ajudar a curar as articulações, ossos, cartilagem, músculos, ligamentos e tecido conjuntivo.
Propriedades citotóxicas:
A citotoxicidade é a capacidade de algumas células de interagir com células alteradas e destruí-las. É por isso que é considerado anticancerígeno e antitumoral. De acordo com múltiplos estudos, tem a capacidade de destruir apenas as células danificadas, ao contrário da quimioterapia, que destrói indiscriminadamente as células boas e afetadas.
Profissionais médicos têm usado extratos de casca, folhas e frutas há muito tempo para tratar seus pacientes de todos os tipos. Os últimos estudos indicam que a sua composição química não só serve para tratar doenças terminais, mas também tem grandes propriedades anticancerígenas.
Esperanças e expectativas estão a aumentar gradualmente em relação à solução para este problema global conhecido como cancro. Esta árvore tem sido objeto de estudo em muitas investigações médicas e todas indicam que aqui pode ser a chave para a cura, devido às suas indiscutíveis e múltiplas propriedades curativas.
O Instituto Nacional do cancro, em 1976, destacou que as folhas desta árvore são compostas de uma substância química chamada acetonononina amonaceus (acetogeninas), que contém altas propriedades anticancerígenas. Este composto químico torna as folhas 10.000 vezes mais tóxicas para as células cancerosas, (ainda mais letal que a própria «adriamycin», uma droga amplamente utilizada em tratamentos de quimioterapia).
A diferença entre a quimioterapia e a medicina natural é que a primeira ataca deliberada e indiscriminadamente todas as células, destruindo tanto as danificadas como as boas. Em vez disso, a gravioleira só destrói as células cancerosas. Ao destruir apenas as células afetadas, os temidos efeitos secundários dos tratamentos químicos como náuseas e queda de cabelo são omitidos.
Vários estudos têm sido realizados para demonstrar os benefícios deste anticancro. A mais recente delas foi realizada em 2012, e foi publicada na Cancer Letter, onde foi afirmado que as propriedades citotóxicas desta planta são altamente benéficas para o cancro de pâncreas, um dos mais complicados de tratar.
Este estudo foi conduzido por um grupo de pesquisa do Departamento de Bioquímica e Biologia Molecular do Centro Médico da Universidade de Nebraska. E de acordo com a pesquisa, seria capaz de matar as células cancerosas do plasma graças à inibição do metabolismo celular. Ou seja, alteraria o metabolismo das células, impedindo que os sinais entre elas atinjam um bom fim, impedindo assim o seu crescimento, produção, vida útil e mesmo a propagação do cancro (a conhecida metástase).
Em 2011, foi publicado outro estudo na revista Nutrition and Cancer, onde os cientistas mostraram que também poderia reduzir o crescimento do cancro da mama sem afetar os tecidos saudáveis, ao contrário da quimioterapia. O estudo foi realizado com ratos que tomaram 200 mg de extrato desta planta por cada quilograma de alimento consumido na sua dieta, durante um período de cinco semanas. Terminado esse período, observou-se uma redução na expressão de uma proteína tumoral da mama, o que levou a uma faixa de redução do crescimento tumoral para 32%.
É também um agente antimicrobiano de alta qualidade, reduz a pressão arterial elevada e é utilizado para a depressão, stress e perturbações nervosas. É amplamente utilizado na medicina tradicional pelos seus agentes tranquilizantes e sedativos. Os extratos possuem três compostos químicos chamados alcalóides (anonaina, nuciferina e assilobina) que, na prática, têm sido capazes de inibir a ligação da [3H]rauwolscina (um estimulante do sistema nervoso e dos recetores T-HTergit e 5-HT1A, que estão encarregados de controlar a pressão arterial e a frequência cardíaca. Isto implica que a fruta Annona muricata tem efeitos antidepressivos.
Referências: Ioannis, P; Anastasis, S. y Andreas, Y. (2015) Graviola: A Systematic Review on Its Anticancer Properties.